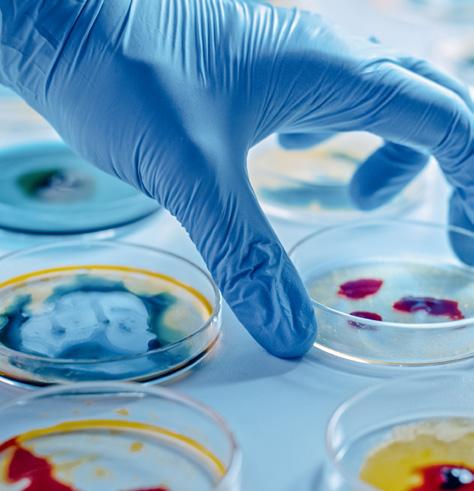

WHAT'S INSIDE
Use the ASVAB CEP to match your skills and interests to possible careers.
AND
4 pathways presented in ASVAB CEP: college, work-based learning, the federal government, and the Military.
![]()
Use the ASVAB CEP to match your skills and interests to possible careers.
AND
4 pathways presented in ASVAB CEP: college, work-based learning, the federal government, and the Military.

“I consider it to be a really solid career exploration system. It has all the components you’re looking for. It’s based on one of the best-researched, most validated assessments out there.”
DR. ROD MCCLOY
, Principal Staff Scientist, Human Resources Research Organization
"We've been using ASVAB for several years now, and I think one of the things I love the most about it is the breadth of careers it exposes students to. It's much stronger than many other career platforms, and the fact that it's free and easy to use is a great asset to our school."
JULIE HILL, Western Boone High School, Indiana
"All of my students take it, and the results that they get help steer them in a direction that maybe they didn't think about originally. It gives very good information about the students' current skill sets and future career paths. My students like that it's not just reading and math, it's not just testing your basic skill set, but there's mechanical, and they enjoy that.
"Look at it as a tool that will help your kids expand their future, expand their knowledge of themselves, and just help them make more informed decisions."
PAULA REED, Northeast Technology Center, Oklahoma
“There’s a stigma that it’s just a military test, but, in my opinion, it's the best career test.”
KATHY HASSLER, Assistant Principal, Cumberland County High School
“My daughter ended up in Biomedical Engineering. Before taking the ASVAB CEP, she didn’t even know what it was. It then found and recommended specific colleges and scholarship opportunities for her as well.”
"I am a big proponent of using ASVAB in the classroom. Number 1, because it helps our students prepare for not only their SAT or ACT but for those students who have no idea what they want to do, it's a really good introduction to career pathways."
DR. ANDREA BEVERLY, Hillsborough County Public Schools, Florida
"I would have students who would take the ACT or other standardized tests, and it just wasn't a good representation of who they were. Once they took the ASVAB, it opened their eyes to other careers, and we would have people come in and do the interpretation. It was just amazing to see them realize all of their different options."
DR. BECKY MEIDINGER, University of Mary, North Dakota
"[The ASVAB CEP] is really important right now because of the Every Student Succeeds Act. Many schools are now expected to supplement the educational experiences available to their students, and career exploration is the way to go. This is the time for ASVAB CEP, and it's worth a look."
DR. ROD MCCLOY, Researcher, Virginia
“It not only verifies when a kid has chosen the right career path, but it also provides options for kids with no idea what career best suits them. The CEP allows students the opportunity to start the exploration process or continue previous exploration.”
KRISTI PARLIER, Jay M. Robinson High School, Concord, NC
"It skyrocketed my daughter's interests and motivation, and now she is pursuing that career [she discovered through ASVAB CEP].”
"This is a world-class career exploration program that helped my daughter and my oldest son make clear, focused, and datadriven decisions about their career pathways that led to declaring a major once, and sticking with it."
ASVAB is an acronym for Armed Services Vocational Aptitude Battery to measure strengths and potential for future success. First introduced in 1968, it was normed using the scores from men who served in the Army during World War II. All military service branches later adopted it in 1976. When given as part of the Enlistment Testing Program at Military Entrance Processing Stations (MEPS), the ASVAB is used for recruiting purposes only.
As research into the test’s validity grew, it became clear that it also applied to civilian occupations, and in 1992, the Student Testing Program (also known as the ASVAB Career Exploration Program (CEP)) was born. HIgh schools, community colleges, job corps centers, and correctional facilities use the ASVAB CEP today for career exploration.
The ASVAB CEP for high school students is a free aptitude test and comprehensive career exploration resource designed to help teens assess their skills and interests and find careers that align. Postsecondary and high school students in 10th through 12th grade can access the federally funded ASVAB and its companion resources.
We like to tell everyone that the ASVAB CEP is more than an assessment — it's a comprehensive career exploration and job readiness program. This program empowers students to discover occupations aligned with their skills and interests and chart a path to a career where they'll thrive.
The ASVAB CEP helps students find where their strengths lie in:
• Civilian jobs
• Professions requiring advanced degrees
• Skilled trade careers
• Military jobs
• Government jobs
The Parent’s Guide to College Planning
Career Exploration with Your Teen Three Common Misconceptions About the ASVAB
6 Reasons to Take the ASVAB and Use the ASVAB CEP
Maximize the ASVAB CEP
ASVAB Test Prep
Understanding Your Teen’s ASVAB Score
Taking the FYI: A Tutorial
Choosing a Career: Work Values
2. The Parent’s Guide to College Planning
The OCCU-Find: Career Exploration for Youth
Career Planning Tools Tutorial
5. Career Exploration with Your Teen
8. Three Common Misconceptions About the ASVAB
9. 6 Reasons to Take the ASVAB and Use the ASVAB CEP
10. Maximize the ASVAB CEP
12. ASVAB Test Prep
14. Understanding Your Teen’s ASVAB Score
16. Taking the FYI: A Tutorial
19. Choosing a Career: Work Values
21. The OCCU-Find: Career Exploration for Youth
23. Career Planning Tools Tutorial

hough your child is now a young adult, as a parent, you still play an essential role in guiding and supporting them as they transition into adulthood. Helping them prepare for and apply to college is a big part of this transition.
No matter how independent and motivated, all students need help with the college application process. First, you’ll need to understand the current process. Even if you attended college, it may differ from your past experiences. If your student is a first-generation college student, the process is all new to you, too.
THE PARENT’S ROLE IN THE COLLEGE APPLICATION PROCESS
#1. Let your student take the lead, but offer help and show your support. Give your student the independence to make decisions while offering help researching colleges or scheduling test dates. Offering support — while avoiding taking over the process — allows them to practice independence.
#2. Don’t compare your student to others or let your desires influence their college decisions. Comparisons to others or imposing your expectations can hinder your student's unique path. Respect their choices and manage their expectations for a smoother postsecondary planning experience for you both.
#3. Encourage your high school student to pursue their strengths and interests.
Support your student in exploring their passions. If your student wants to learn more about their skills and interests, suggest they participate in the ASVAB Career Exploration Program (CEP). This free, comprehensive planning tool helps high school students identify their strengths, determine their interests, and search for occupations aligned with both
Check with your student’s high school guidance counselor to see if their school offers the ASVAB CEP. If not, tell your school counselor your student would like to take the assessment
Many schools and websites offer free college prep instruction to help teens with applications. These workshops are excellent resources for learning the details about the application process, what admissions officers look for in applicants, how to write a college essay, how to pay for college, and more
No matter how much you know, there’s always more to learn. Staying informed can help reduce stress.
Discussing money with your student can be difficult but crucial for college planning. You can start this conversation by addressing the following questions:
•How much can you afford if you’re contributing to your child’s higher education?
•Is there a college savings account to cover expenses?
•Who will pay for tuition, room and board, books, and living expenses?
•How much do you expect your student to contribute financially?
•Will they need to take out loans for part or all of their education?
Complete a Free Application for Federal Student Aid (FAFSA) regardless of your family's financial situation. It is typically due by the end of June prior to the fall semester your student will start college, but most schools require it earlier. FAFSA recommends completing the form as soon as you've completed taxes — the sooner, the better. Those applying sooner tend to have more financial aid available to them than those who wait.
Scholarships are a great way to offset college costs. Many scholarships are available, though researching them takes time. Criteria vary, but scholarships are generally need-based, academic, community service, athletic, or identity-based. Encourage your student to apply, as the extra effort can really pay off. Begin searching the summer before junior year to get ahead of college application deadlines.
Learn more about applying for scholarships
Your teen should start participating in extracurricular activities when they begin high school. Encourage your student to pick at least two things they enjoy and can stick with. Depth looks better on college applications than dozens of short-lived pursuits.
Learn more about why your student should participate in extracurricular activities.
The coronavirus pandemic forced many colleges and universities to make standardized test scores optional in 2020, a trend likely to continue through 2025. However, taking the SAT or ACT still benefits those seeking merit scholarships. Your student should take these tests early in junior year, which leaves enough time for retakes, if necessary.
Research admitted students’ average standardized test scores at the schools your student is considering. This data will provide a benchmark goal for the scores needed for admission.
Many high schoolers take ACT or SAT prep courses or work with specialized tutors. However, these options aren’t the only choices. Many high schools offer supplemental classes or workshops; check online for free or affordable resources like test prep websites and books. For example, March2Success is a free online study program that helps students prepare for standardized tests, improve school work, and review materials.
Any test prep will teach your student invaluable tips and tricks.
The college application process has many deadlines. Keep your teen on track by adding test registration, testing dates, and application deadlines to the family calendar.
While you can’t take the tests or apply to college for them, collaboratively managing their schedule alleviates some of the pressure.
Once your student shortlists their top schools, visit as many as practical in person before applying. What seems like a good fit on paper may feel less appealing once your teen tours the campus, feels the vibe, and notices details not evident in glossy advertisements or websites. Start visiting colleges either before or early in their junior year. Check out these tips for maximizing your college visits
Admissions officers use the college application essays to evaluate applicants. These essays differ in style and tone from typical school papers and can cause stress for students not used to writing this way. High schools often offer workshops, and many online resources are available. You can help by reading prompts together, brainstorming ideas, and finding topics highlighting their character or achievements. Ask someone experienced, like a teacher, to proofread their essay. Share these tips with your student on writing a strong college essay
Once your student has their materials prepared, encourage them to apply to more than one or two schools. According to the Huffington Post, most teens apply to between five and seven schools. A good rule of thumb is for students to apply to each type of school:
Safety Schools: Colleges likely to accept them
Target Schools: Colleges or universities aligned with their grades and test scores
Reach Schools: Institutions a bit out of their reach in terms of grades and test scores
Think about applying for early admission. Most schools have early admission deadlines in the fall, but choosing this option can bring benefits like knowing where your teen will go. Applying early means getting a decision before January 1, easing later stress. Be sure to read the fine print; many students who apply early decision signal their commitment to attend that college or university, and it is difficult to change their mind later.
Whatever decision your teen makes, be sure to support their chosen path. They might not say so, but your acceptance and pride mean the world to them.
When they finally get that long-awaited acceptance letter and choose, buy the college t-shirts, bumper stickers, and gear. Showing pride in their achievement will mean more to them than you know.


If your teen took the ASVAB at school, they can do everything the ASVAB Career Exploration Program (CEP) offers at home. The ASVAB CEP allows you and your teen to access program resources online together, all from the comfort of your living room!
After taking the ASVAB, participants receive a unique access code on their ASVAB Summary Results (ASR). Students use this code to create an account at asvabprogram.com and launch their individualized career exploration. Parents can also create an ASVAB CEP account (more on that later) to see what their
teen sees on the website and complete activities together. Note: students who lost or misplaced their scoresheet can request scores (and their access code) here
Despite their protests, most teens do care what their parents think! Your opinion matters, so talk with them about their next steps to help them make the best choice for their future. The ASVAB CEP tools and resources can guide your conversation, whether your teen chooses to attend college, join the Military, or complete work-based learning after high school.
Create your own account using the access code PARENT. Setting up your account gives you access to all the resources on the ASVAB CEP website and lets you assist your teen with their career exploration. Watch the tutorials on the website to begin. Also, check out the parent-focused articles in the ASVAB CEP Parent Article archive.
Discuss your teen's options as you explore the ASVAB CEP together. They might discover new career possibilities by using their ASVAB and assessment scores to guide their search in OCCU-Find. So many choices and potential pathways to entry can spark conversations about important topics and raise questions. These articles can guide further discussions and provide some answers:
•Higher education is expensive! How can I afford the cost of college?
•My teen is interested in joining the Military. Where can I get answers to my questions?
•My teen doesn’t want to go to college. What are the alternatives to college?
•My teen wants a tattoo. Will it affect their employability?
•What is a gap year, and how could it benefit my teen?
Log into asvabprogram.com and click Step 3 on your dashboard to find Classroom Activities. Despite the name, these resources are excellent at-home tools for teens to develop professional skills and increase their awareness of the working world. Channel your inner “career explorer” and ask your teen to share these activities with you, or better yet, complete them together:
•Virtual Job Shadow
•Cost of a Career
•Cost-Benefit Analysis
•Elevator Pitch Video
•Create a LinkedIn Profile
•Family Career Tree

Supporting your teen’s path starts with guiding them to define their goals. Here are some steps to get you both started:
Managing expectations is key to understanding that college isn’t suitable for everyone. Help your teen understand the work involved in achieving their goals. To start, set up short-term milestone goals together.
You may have set SMART goals (Specific, Measurable, Achievable, Relevant, and Time-Bound) in your own personal or professional life. If so, you know this is a valuable life skill for your teen.
Talk regularly with your teen about their goals and how they might evolve. Chats like these show them you care. As your teen works on their plan, check in with them and see where you can offer support.
Regardless of your teen’s post-graduation plans, you will continue to play a critical role in helping them achieve their future goals.
Whatever their path after graduation your teen will have to talk to a professional, be it a college or military recruiter or potential employer, tasked with making decisions about their future. You can help your teen prepare for meaningful conversations with decision-makers with this article.
If your teen chooses college, this guide on the parent’s role in planning will help support the transition. Ensure your teen understands what college application involves and aligns their college choices with their ultimate career goals.
Your teen must consider many factors, take many steps, and conduct research when applying to college. Let them lead on legwork while you make suggestions and support their efforts. Here are some tips for getting started on the college application process:
•Encourage your teen to identify institutions offering programs of study related to their careers of interest.
•Schedule an in-person tour. Read more about getting the most out of college visits
•Offer to proofread their application package, but don’t rewrite their work.
Many students enter the workforce right after high school, either with a first job, an apprenticeship, or a work-based learning program. While college has become the “gold standard” in the eyes of many, going straight to work has many advantages. Skilled trade careers offer young adults the opportunity to enter in-demand occupations with lucrative pay and job stability. Prepare your teen for entering the workforce by sharing your own experiences with interviews, job hunting, and employment.
Encourage them to research and develop questions about companies of interest and the employment benefits they offer, like health insurance, retirement, and room for advancement. You can also help them assemble their first resume or practice interviewing with sample interview questions
If your student wants to join the Military, you may have many questions and perhaps some concerns. The Military offers many benefits, but it also expects a serious commitment.
Support your teen by reviewing the benefits of military service and entrance requirements and openly discussing their reasons for joining. If you don’t come from a military service background, encourage your teen to speak with a family member or friend who has served. These conversations are the best way for you both to understand military life
You also can learn more about enlistment options, requirements, and more here
There is no single path that’s right for everyone. Your student’s choices after high school are not mutually exclusive. Many people pursue a combination of options (college, the Military, and work-based learning) to achieve their goals.
As your teen becomes an adult, you will remain one of the most influential people in their lives. Regardless of your expectations for your teen’s future, what truly matters is that your teen finds a career sparking happiness and satisfaction. The best way to prepare them for the working world? Supporting their passions, understanding their goals, and becoming their biggest cheerleader.

The ASVAB CEP is only for those interested in the Military.
A commitment to military service is NOT required to participate in the ASVAB Career Exploration Program. While the ASVAB was originally designed for military entrance and job classification, it’s only one component of the Career Exploration Program. The career planning tools and resources available to students after taking the ASVAB are the true benefit of program participation.
The ASVAB CEP incorporates all career paths and all professional field entrance criteria in one location, including college, work-based learning, the federal government, and the Military. It helps students learn about their skills and interests, research career options and pathways, and create action plans. The program’s tools focus on civilian careers and military-related options; however, speaking to a recruiter is not required to participate in the ASVAB CEP.
The ASVAB doesn’t count for college admissions, so students shouldn’t take it.
The ACT and SAT measure achievement and many colleges require them as part of the admissions process. The ASVAB is different in that it measures a person's aptitudes and the skills they have learned or can acquire. ASVAB scores can help students understand which skills they can learn and improve. These scores also help students identify potential careers aligned with their strengths.
ASVAB scores are combined to yield three Career Exploration Scores: verbal, math, and science/technical skills.
Students use these scores when exploring jobs in the OCCUFind. Their career exploration scores are good indicators of their potential for success in further education, training, and occupations. They focus on skills (typically learned and modifiable) rather than on achievement (which is often seen as fixed).
In addition to knowing their strengths, students can identify their top career-related interest areas using the Find Your Interests (FYI) Inventory and their primary workplace preferences using the Work Values Situational Judgment Activity. Students can use the results from these combined assessments to Leveraging the results from these combined assessments as they explore the OCCU-Find and identify helps students identify which career fields best suit their unique skills, interests, and values and identify college options related to those careers.choose a major in which they’ll be successful.
The ASVAB CEP is identical to other career tests.
Many career tests are fee-based programs that either examine a single aspect of a person's personality or focus on one post-secondary pathway (i.e., college). The career quiz makes recommendations based on that evaluation. These assessments can be inconsistent and limit students’ perception of their postsecondary options.
Loving molecular biology doesn't automatically make students a lab whiz (skills matter!), and being a TV star doesn't require a college degree (although it can help!).
By contrast, the ASVAB differs from other career aptitude tests for high school students because it assesses skill and training potential. Plus, it’s free to students and schools and includes a post-test career counseling session: the Post-Test Interpretation (PTI).
The PTI is arguably the most valuable aspect of the ASVAB CEP. During a 45-minute session, a trained expert explains the scores, including their significance and potential use in career research. The expert also shares all the resources available at asvabprogram.com, including those above.
Once students have identified careers they want to learn more about, the program offers the tools to translate their interests into a concrete action plan. The Career Plan, My Portfolio, My Educational Plan, and My Coursework Planner are great places to start.
If you’re the parent of a high school student, you’ve probably talked about their post-high school plans. Has your child begun to explore their post-secondary choices? Are you and your student aware of all of the options available?
The ASVAB Career Exploration Program (CEP) is much more than a military test. Regardless of their future career plans, students in grades 10-12 can take the assessment. The program helps students learn about their skills and interests, identify potential occupations, and discover all the pathways to career-field entry.
The ASVAB measures skills and strengths that can improve over time. Subtests within ASVAB cover traditional subjects like math and English and other topics students might be less familiar with, like mechanical comprehension and electronic information. Learn how the ASVAB is scored here
The ASVAB CEP has additional resources and assessments, including the Find Your Interests Inventory, to help students uncover work-related interests and preferences.
The ASVAB is just the first part of the ASVAB CEP. Career satisfaction depends on doing something you’re good at (aptitude) and enjoy (interest). The ASVAB CEP helps students determine both and explore occupations and career pathways and includes three main components:
•The ASVAB (an aptitude test)
•The Find Your Interest Inventory (FYI) and Work Values Situational Judgment activity
•The OCCU-Find career exploration
Students can also access planning tools like My Portfolio, My Education & Career Plans, and My Coursework Planner. These resources help students understand themselves and the working world so they can make informed career decisions.
Most states require high school students to demonstrate their graduation readiness. Many states accept the ASVAB to satisfy these graduation requirements. School counselors can use the ASVAB CEP activities to comply with career exploration requirements.
The ASVAB measures aptitude (how well students have developed their skills) and assesses their training potential. While initially introduced as a predictor of trainability in military occupations, ASVAB results show applicability to ALL civilian and military career fields.
Every ASVAB participant receives scores used to guide career exploration on asvabprogram.com. Students in 11th grade and beyond also receive an AFQT score to use for enlistment if they choose.
Schools participating in the ASVAB CEP select from eight score release options, which dictate the release of scores to recruiters. Your child can opt in or opt out of that option by completing the appropriate form. Participation in the ASVAB CEP doesn’t require your teen to speak with a recruiter.
The ASVAB CEP focuses on broadening options for more meaningful, informed planning. It’s the ONLY program presenting all career entry requirements and pathways, including college, work-based learning, and the Military.
Most standardized tests are fee-based and don’t offer complete planning resources. Schools and individual students receive free access to everything the ASVAB CEP offers. If your child’s school doesn’t currently participate, click here to send information about the program to your school’s counselor.

Your student took the ASVB! That's great, but it's just the first step in the Career Exploration Program (CEP).
The most important part comes next: the Post-Test Interpretation (PTI). The PTI includes detailed score explanations, work-related assessments, and guided career exploration. Students and
educators also gain access to ASVAB CEP tools like the Portfolio, resume builder, and classroom activities to help students define their career goals. Best of all, the ASVAB CEP, PTI, and all related tools are free to students and schools.
For maximum benefit from the ASVAB test, your student should schedule a Post-Test Interpretation (PTI) because the ASVAB Summary Results Sheet (ASR) means very little without understanding the scores’ meaning.
A professional meets with your student in a 45-minute PTI session to explain their ASVAB scores and show them how to use them for exploring career options and planning for the future. Your student will use the access code from their ASR to create a free account at asvabprogram.com. Then, they can take various self-assessments and take advantage of other ASVAB CEP resources, including post-test activities
The ASVAB CEP offers a hands-on PTI session to ensure students understand and use their ASVAB scores and ASVAB CEP resources to investigate career pathways.
The PTI occurs after students complete the ASVAB (P&P ASVAB) and receive their results. Paper-and-pencil ASVAB results arrive in about two weeks, so schedule the PTI accordingly. Students who take the CEP iCAT (Computer Adaptive Test) receive instant results, so they can schedule the PTI at the school's convenience, potentially on the same day.
A trained education professional leads the PTI session, designed to inspire and engage students. The session includes detailed ASVAB score interpretation and interactive demonstrations, fostering self-discovery and informed career planning. Students can also explore ASVAB CEP’s online tools and ask questions.
Students first create an account on the ASVAB CEP website using their unique access code from their ASVAB ASR. In the PTI session, an education specialist explains the ASVAB, its subtests, and ASR scores and guides students through the 90-question Find Your Interests (FYI) inventory based on John Holland’s RIASEC model and Theory of Career Choice. Students learn which of the six RIASEC personality types match their interests to identify suitable career opportunities.
Next, students complete the 16-question Work Values Situational Judgment Activity to determine their workplace values. These three tools provide a comprehensive self-assessment, crucial for the next steps in career planning.

With self-assessment insights, students explore careers using the OCCU-Find Database. This tool, designed for young adults, offers thousands of options. Users can search based on their assessment results or explore known occupations. Each career detail page includes job interest codes, skill importance ratings, associated work values, specific tasks, and information about required education, credentials, licenses, apprenticeships, and military pathways. Students can also add interesting careers to their favorites. This list becomes important in the next step when students build their post-secondary plans
The PTI session focuses on learning and exploring and also helps your student execute their goals. In the final step, students use ASVAB CEP’s career development tools to create an action plan. The PTI facilitator guides them through the Plan Your Future Dashboard, how to use the Create A Career Plan tool, and demonstrates the customizable calendar and checklists. Students also learn to use the Portfolio to document accomplishments, track test scores, and create a resume to share with teachers, parents, and potential employers.
After the PTI session, students can access their ASVAB scores and ASVAB Career Exploration Program resources for two years. This ongoing support helps them gather information and adjust career plans. Using the FYI, OCCU-Find, and ASVAB CEP Career Planning tools with their PTI insights prepares students to successfully navigate their chosen career paths.

You’re probably thinking, “Umm, shouldn’t my student just study?” Actually, there’s no need to study for the ASVAB.
The ASVAB differs greatly from typical tests your student takes. Unlike a calculus or AP exam, you don’t pass or fail the ASVAB because the test's purpose is not to measure achievement.
The ASVAB measures current knowledge and acquired skills to predict potential success in three areas: math, verbal, and science/technical.
While you don’t need to study for the ASVAB, many students still want to know what the test entails and what to expect. Reviewing practice ASVAB tests offers a helpful sneak peek, and you can find plenty of resources with ASVAB practice tests and sample questions.
Because the ASVAB differs from other tests, there’s no such thing as a “good score.” The ASVAB test generates three sets of scores: percentile and standard scores and score bands. Learn more about ASVAB scoring in this article.
Your student may take one of two test versions: traditional paper-and-pencil or the computer-adaptive iCAT. While both versions are scored similarly and have similar subtests, some key differences exist.
Paper-and-Pencil Administration
For the traditional paper-and-pencil (P&P ASVAB) test, participants physically enter their scores onto their test sheets. All participants complete the same subtest(s) simultaneously in about three hours.
The CEP iCAT is an adaptive test taken on a computer. Because the test is adaptive, participant responses determine the complexity of the next question. In other words, the test adapts to each examinee’s ability level.
Unlike the paper-and-pencil ASVAB, the iCAT is self-paced. Students move on to the next section as they complete the previous one. They don’t need to wait for the other test-takers to complete the section. The iCAT has fewer questions and takes approximately 90 minutes to complete (about half the time of the paperand-pencil version).
We recommend reviewing the Strategies for Taking the ASVAB with your student to help them prepare. Regardless of which version your student takes, keep these general tips in mind:
•Read the directions for each subtest carefully before beginning.
•Read each question carefully before selecting an answer.
•Watch the time. Don't spend too much time on one particular question if that means there won’t be time to answer later questions.
When you don't know the answer to a question, try to rule out as many incorrect choices as possible and make an educated guess from the remaining options.
The ASVAB consists of a series of subtests that assess specific abilities. The paper-and-pencil test contains eight sections, and the computer-based iCAT has nine subtests. The ASVAB sections include:
•General Science
•Arithmetic Reasoning
•Word Knowledge
•Paragraph Comprehension
•Mathematics Knowledge
•Electronics Information
•Mechanical Comprehension
•Auto & Shop Information
•Assembling Objects
The total number of questions on the ASVAB depends on which version of the assessment your student takes. The paper-andpencil ASVAB has 200 questions, and the iCAT version has 145 questions. The paper-and-pencil version has 15 to 35 questions in each subtest, while the iCAT has 11 to 16 questions per section.
The table below shows the number of questions in each ASVAB subtest section.

On test day, bring one form of identification. The test administrator will provide number two pencils, test materials, and scrap paper. Calculators are not allowed on the ASVAB, so leave them at home.


Your student has taken the test and has their results. What do all the scores mean? The ASVAB Summary Results (ASR) sheet shows three different types of scores:
•Career Exploration Scores
•ASVAB Subtest Scores
•AFQT Score
Your student’s ASR includes three Career Exploration Scores:
•Verbal
•Math
•Science/Technical
Each score highlights your student’s strengths in that area and is based on a combination of the ASVAB subtests. Once your student starts using the ASVAB CEP, they can use their Career Exploration Scores to explore the OCCU-Find and discover careers aligned with their skills.
The ASVAB consists of eight subtests (nine if you take the computer-based test). Your student receives a score for each subtest, indicating your specific areas of strength or improvement. Color-coded ASVAB subtests indicate which subtests comprise each Career Exploration Score.

The Military uses the Armed Forces Qualification Test (AFQT) score to calculate a test taker’s eligibility for enlistment. Even students not interested in joining the Military receive this score.
Four ASVAB subtests' scores (Arithmetic Reasoning, Mathematics Knowledge, Paragraph Comprehension, and Word Knowledge) determine the AFQT score. Qualifying AFQT scores can change based on each service branch’s evolving needs. Each service and military career has different entry requirements. Each military branch uses service-specific line scores and AFQT scores to determine eligibility for military jobs.
Junior, senior, or post-secondary school students can use their ASVAB CEP scores to explore military enlistment up to two years after taking the test.
The ASVAB is scored differently than other tests your student has taken. Unlike other tests measuring achievement, this test measures knowledge and acquired skills. The scores don’t represent the percentage of correct answers. Instead, they compare your student’s scores to those earned by others taking the test.
Unlike SATs or ACTs, which score efforts based on the percentage of correct answers, percentile scores indicate how your student’s scores compare to others in the same grade and of the same and opposite genders. ASVAB percentile scores range from 1 to 99.
The Standard Score (in the far right column of the ASR above) is also called the ASVAB Composite Score. These scores show where your student’s scores fall relative to the national average of those in their grade level who also took the test. With ASVAB Standard scores, most students score between 30 and 70.
An average ASVAB score falls around 50 on the standard score scale. Scores above 60 are considered above average. According to OfficialASVAB.com, about half of young adults ages 18 to 23 score at or above the standard score of 50, while only 16% reach or surpass 60. There is no minimum ASVAB score.
The gray shading around each score in the center section — the Standard Score Bands — shows the score range your student is likely to earn if they retake the test without additional preparation.
The ASVAB Summary Results sheet includes an access code for your student to log into asvabprogram.com. Here, they will find all the career planning features of ASVAB CEP and their ASVAB scores. The website has many valuable tools for career exploration and post-secondary planning, including:
•The Find Your Interest (FYI) Inventory: A short assessment that helps your teen understand how their interests relate to occupations.
•The Work Values Activity: A tool to help your teen identify what they value in the workplace.
•The OCCU-Find: A career catalog that allows your teen to search for occupations based on their ASVAB results, interests, and more.
•Plan Your Future Dashboard: A unique planning tool that helps compile their achievements and create an action plan for your future goals.
Look on the ASVAB Summary Results Sheet for your student’s ASVAB scores or request your ASVAB scores online here
ASVAB scores are calculated differently depending on which version of the ASVAB test your student took: the iCAT (computerized adaptive test) and the pencil-and-paper (P&P) test.
The iCAT uses a scoring algorithm to measure the difficulty of correctly answered questions and weighs them against the number answered correctly across all subtests.
Pencil-and-paper ASVAB scores are based only on the number of correctly answered questions across all subtests. Each correct answer earns one point. There is no penalty for incorrect answers, so answering every question is beneficial.
There is no such thing as a good ASVAB score; ASVAB CEP participants don’t pass or fail. The ASVAB measures abilities and strengths, not achievement.
While a 50 might be a “failing grade” on a typical test, the ASVAB considers a score of 50 average. Scores differ based on strengths, proficiency, age, and gender.
Although they can’t pass or fail the ASVAB, if your student is considering a military career, they may want to earn a particular score depending on their desired service branch and job. The score requirements for an Army mechanic differ from those for a naval navigator, for example. Your best bet is to speak with your student and a military recruiter about their goal and discuss the required AFQT score.
To improve a specific score, review which ASVAB subtests comprise that score and focus your studies on those topics.
Schedule a post-test interpretation (PTI) session where your student can talk to an education services specialist (ESS). This specialist will give them a comprehensive explanation of their ASVAB scores, detail their significance, and provide guidance on their application.
Click here to bring the ASVAB CEP to your school or ask your school to schedule a PTI and bring the complete ASVAB Career Exploration Program to your school.

The ASVAB Career Exploration Program’s (CEP) Find Your Interest (FYI) Inventory is designed to help your teen discover their vocational interests. This quiz asks about the activities they enjoy to determine interests and passions that relate to specific occupations. Knowing these interests will help your teen find an enjoyable career field and increase their chances of job satisfaction.
This tutorial demonstrates how to take the FYI and explains the inventory results. Keep reading for a more complete overview.
The ASVAB CEP FYI Inventory is derived from the RIASEC© model, John Holland's Theory of Career Choice based on personality types. Understanding your teen's personality type allows them to explore careers and job descriptions aligned with their interests.
Your teen should use the access code from their ASVAB Summary Results Sheet to log into ASVABprogram.com. From the main dashboard, they can navigate to the “Learn About Yourself” tab and select “Take the FYI.”
Completing the interest inventory requires your teen to select the answer that best describes their feelings about each activity. There are no right or wrong answers. But please advise your teen to respond quickly and go with their gut reaction to get a more accurate score of their personality traits pertaining to work-related interests.
While the quiz includes 90 questions, it takes just a few minutes to complete.
After answering all the questions, your teen should select their gender before clicking “Next” to view their results. (Selecting gender is important for determining interest codes because societal and media messages often differ between genders and could influence your teen's specific interests.)
While a male student's Social score might appear low compared to the overall average, it could still be high relative to other males. Similarly, a female student's Realistic score could be lower overall but higher relative to other females.

Teens who specify a gender after taking the FYI receive two sets of interest codes: Combined and Gender-Specific. Those who do not specify a gender receive only one set of interest codes. Each list includes three dominant interest codes highlighted at the top.
Combined Scores show your teen’s three strongest interest areas based on how their results compare with other high school students who have also taken the FYI.
The Gender-Specific scores compare your teen’s FYI results with those of the same gender. Reviewing these results may highlight new careers for them to explore within these interest areas.
Your student should choose the set of interest codes that best suits them to begin career exploration in OCCU-Find, ASVAB CEP’s next activity. Their top three interest codes always appear on the upper right-hand side of the page and can be updated at any time.
The FYI interest codes correspond to the six personality types of the RIASEC© model:
Realistic: Practical, straightforward, and persistent
Realistic individuals generally have good mechanical and physical skills and enjoy working with things (machines, plants, and animals, for example) rather than people.
Investigative: Curious, observant, and logical Investigative types usually have strong math and science skills and prefer to work with ideas rather than people or things.
Artistic: Expressive, original, and independent
Artistic personalities are creative and have robust imaginations. They often thrive in settings where they can work without defined rules.
Social: Friendly, outgoing, and helpful
Social people have strong communication and people skills. They enjoy working with people more than machines or information.
Enterprising: Persuasive, ambitious, and energetic
Enterprising individuals typically like to work with people and ideas rather than objects or machines. They like fast-paced work environments, jobs with a lot of responsibility, and decision-making roles.
Conventional: Efficient, methodical, and detail-oriented
Conventional types prefer working with data and using precise standards in their work. They usually have solid clerical, organizational, and arithmetic skills.
To learn more about these interest types, visit “Learn About Yourself ” on the ASVAB CEP website and scroll down to “Interests” on the student page.

USE FYI RESULTS TO CHOOSE
After your student finishes the FYI, they should complete the Work Values Activity found within the tab “Learn About Yourself” on the My ASVAB Dashboard. This quick assessment determines workplace preferences and will help your teen see the most complete picture of themself before they begin exploring careers.
Now it’s time to discover careers that match your skill set, interests, and work preferences! Use the OCCU-Find in the “Explore Careers” tab to search for occupations using their specific ASVAB test scores, FYI interest codes, and Work Values results. Your teen can also explore careers best suited to their individual wants and needs, as determined by their ASVAB CEP assessment and tools.

An
ASVAB CEP tool to help you learn about your workplace preferences
Choosing a career is a big decision. Thousands of options exist, and many high school students feel pressured to decide on a career path before they have much exposure to the working world. How can they possibly know, as teens, what career would bring them happiness and fulfillment?
Your student should ask:
•Do I thrive when I receive recognition, feel supported, have a chance to work independently, and am part of a great team? Do I need variety and creativity in my work?
The ASVAB CEP activity, Work Values: Situational Judgment, is designed to help your student find answers and learn what they value in the workplace. It helps them rank each work value
category based on priority to align their values with future work opportunities.
The ASVAB measures skills, and the Find Your Interests (FYI) inventory identifies work-related interests. Work values are different from other values. Work values refer to what motivates and keeps you engaged in your work. They differ from person to person — and you can have multiple work values. These values help explain why some people thrive in certain environments, and others don’t.
A job is much more than where you work or what you earn. Each workplace has its own environment, culture, and values. Research shows that the more closely those values match your own, the higher your overall job satisfaction.
Over the past decade, researchers have increasingly studied work values and found that aligning them with real-world situations benefits employees and employers. Employees feel greater work satisfaction, and employers recognize that happiness about one’s work leads to better outcomes and more satisfied employees who are less likely to leave.
If your student already took the ASVAB at school, they can complete the Work Values activity by logging in to asvabprogram.com and navigating to the “Learn About Yourself” tab. The activity should take 5-10 minutes and includes 16 different work scenario questions. Students choose from one of six responses after considering their past work, school, volunteering, and extracurricular activities. There is no right or wrong answer. If they haven’t previously encountered a particular situation, students should imagine how they would respond based on other past experiences.
Work values from the Situational Judgement Activity fall into six categories: Achievement, Working Conditions, Recognition, Relationships, Support, and Independence. When students finish answering the questions, you’ll receive an individualized profile listing your top three work values. Students should use these results to compare careers aligned with their work values in the OCCU-Find career catalog.

Achievement: Those scoring high on Achievement are results-oriented. These workers often pursue jobs where they can apply their strengths and abilities, which generates a sense of accomplishment.
Relationships: Those scoring high on Relationships prefer jobs that provide services to others and partner with co-workers in a friendly, non-competitive environment. These employees value getting along with others and don’t like to be pressured to do things.
Support: Those scoring high on Support value company leadership that stands behind and supports its employees. People in these jobs expect fair treatment from their employers and appreciate supervisors who spend time and effort on training.
Independence: Those scoring high on Independence value taking a creative approach to their work. These employees want to make their own decisions and execute their responsibilities with little supervision from a manager.
Recognition: Those scoring high on Recognition pursue jobs with opportunities for advancement, recognition, and leadership responsibilities. Their peers value them for their contributions.
Working Conditions: Those scoring high on Working Conditions value having plenty to do and expect to be paid well for their efforts. These employees thrive with little or no supervision. They pursue steady employment that offers daily variety whether someone chooses to attend college, join the Military, or complete work-based learning after high school.

he ASVAB Career Exploration Program (CEP) is more than an aptitude test or military entrance exam. This suite of career resources helps participants explore job options and plan for the future. Understanding potential careers gives your student the tools to make informed decisions, ensuring a satisfying career matched to their skills, interests, and values.
The ASVAB CEP also provides access to a database of thousands of occupations. Based on ASVAB results, participants can explore career options, find jobs aligned with their skills and interests, and filter by job category or keyword. The OCCU-Find is a unique, easy-to-use career search tool for high school students and young adults.
Before using the OCCU-Find, watch the tutorial on the website together to understand this powerful tool. The summary below includes helpful information for your teen’s career exploration journey.
After receiving their ASVAB Summary Results, your student can log in to ASVABProgram.com with their unique access code. We recommend they complete the Find Your Interest (FYI) Inventory under “Step 1: Learn About Yourself” to generate career-related interest codes.
Begin their career exploration journey with OCCU-Find by selecting “Start Career Exploration” under “Step 2: Explore Careers.”
Students should begin their job search in the OCCU-Find by choosing up to three interest codes from the FYI. Those three interest codes (which students can change at any time) will appear in the top-right header of the student dashboard. We included this section because studies show that interests are among the most important predictors of career satisfaction.
Your student can also search by their most vital ASVAB skill area (verbal, math, or science/technical), as these strengths indicate potential occupational success. These scores, denoted by the book icons, appear in the top header of the student dashboard.

After your student discovers their interests, skills, and work values and identifies exciting job categories, click “EXPLORE.”
The OCCU-Find generates a list of compatible occupations. Each occupation links to a career detail page displaying important information, including:
•Job description and duties
•Skills needed and related work values
•Available career entry pathways (via education, credentials, the Military, or federal government)
•Employment statistics
•Entry-level salary and average salary information
•Related occupations

The OCCU-Find allows your student to browse careers by interest codes, sort by ASVAB strengths, and filter by work values, categories, and keywords.
Filter by Category
The available OCCU-Find job categories include:
•Bright Outlook: These occupations will experience rapid growth in the next ten years. These jobs also have many openings or are new and emerging occupations.
•STEM Careers: This includes jobs in science, technology, engineering, or mathematics.
•Hot Military Careers: These military careers are in high demand or experiencing growth.
•Available in the Military: These civilian occupations align with similar jobs in the Military.
As your student searches for careers, they can select favorites using the heart icon. They’ll appear in their profile for further research and reference. Once your student creates their list, they can compare favorites side-by-side and create an action plan.
The OCCU-Find and ASVAB CEP help students plan their future with unique career-planning tools. The Career Plan, found under “Step 3: PLAN YOUR FUTURE,” helps your student make a plan to attain their goals.
After identifying a few “favorite” careers, students can build multiple plans to assess the time and resources needed to enter those particular careers. Some careers might require an undergraduate and graduate degree. Others might only need an associate’s degree — and others might require them to attend trade school.
Encourage your student to explore the Portfolio tool, which enables them to create a resume-like document capturing their educational achievements, work experience, volunteer activities, test scores, and more.
Students can download or electronically share their completed resumes via email with educational counselors and potential employers. Students can also use the Portfolio to organize the information needed to complete college and scholarship applications.
The ASVAB CEP is better than ever
“PLANS ARE NOTHING. PLANNING IS EVERYTHING.”
- Dwight D. Eisenhower, U.S. President, Army General, & Statesman
s a parent, you understand the importance of planning to achieve objectives and goals. That's why the ASVAB Career Exploration Program (CEP) continues to evolve, adding new and better tools to help students achieve their career goals.
The ASVAB CEP has long offered career decision-making activities and planning tools for high school students. In July 2023, the program launched additional career planning tools, including:
•Career Plans
•Portfolio
•Calendar
•Classroom Activities

The Career Plan tool allows students to build an intentional action plan with clear steps to achieve their goals and create multiple custom career plans based on their favorite occupations. This ability helps students weigh the effort to achieve their goals.
This practice also helps them think through a Plan B to increase resiliency. To effectively plan for and achieve a bright future, students must understand what steps their chosen career requires. A school counselor or parent can help students evaluate their options and choose the right fit path.
The Portfolio tool allows students to document their achievements, relevant work experience and education, test scores, and skills and customize their resumes to stand out from their peers. The output is a resume-like, downloadable document shared with counselors and parents to facilitate discussions about students’ post-secondary plans. Learn more about using the Portfolio here.
The new Calendar tool allows students to track important dates and manage tasks related to their Career Plans. Some dates and tasks will automatically populate the student’s list based on their favorite careers. The fully customizable calendar also tracks dates and deadlines — SAT and ACT testing, FAFSA application due dates, and military entrance checklists — associated with their specific post-secondary plans.
Students can use their calendars for other important events and tasks, like scheduling time to discuss college budgets or get career counseling from their guidance counselor.
The ASVAB CEP classroom activities are designed to bring career exploration into the classroom (regardless of subject matter) so parents can help students apply academic learning to the real world.
The new dashboard enables students to easily see and complete career exploration activities independently or in class. These activities facilitate meaningful reflection and discussions to help students understand their options and professions suited to their goals and aptitudes.
In addition to the new career planning tools, students can now:
The redesigned dashboard prioritizes user-friendliness and easy navigation. Its enhanced function helps parents consult with educators about their student’s post-secondary plans. ASVAB CEP scores automatically populate in the dashboard for convenient reference. The user experience also incorporates gamification, like a completion icon that motivates students to move through each step and gives clear guidance on remaining tasks.
The Tips section provides students with more information about post-secondary planning, gaining work experience, using CEP tools, and more.
To access the Career Planning Tools, students must take the ASVAB through the Career Exploration Program. Then, they use their access code (from their Summary Results Sheet) to create an account once they log into asvabprogram.com. When they log in the first time, students must add careers to their “Favorites” using the OCCU-Find in the “Explore Careers” tab.
After they’ve selected their favorite occupations, they can use the Career Plan feature.
Step 1: Use the OCCU-Find to explore careers and favorite occupations that interest them.
Step 2: Select their desired career pathways. Since the ASVAB CEP is about options, students can select multiple career entry pathways. Pathway options include:
•Certificate
•Technical School
•Associate’s Degree
•Bachelor’s Degree
•Advanced Degree
•Military
•Work-Based Learning
•Vocational Training
•Career and Technical Education
•Gap Year
Here, students add their expected high school graduation date and list high school courses, extracurricular activities, and work experience related to their desired job.
Each career pathway correlates to a custom module based on the steps needed to complete it. For example, selecting a college degree lets students search for postsecondary institutions offering related majors, find detailed information about each school, and add that college to their career plan.
Other pathway options, such as a gap year, military, or work-based learning, ask appropriate questions and provide relevant information to help guide planning.
Once students complete the previous sections, they’re prompted to add important dates and tasks. They can add submission deadlines for scholarships, testing dates, college application deadlines, or reminders to meet with their guidance counselor.
Finally, students can add their own notes about careers, research, or anything else for future reference.
Completing these steps gives your student a clear, actionable plan to reference through the website or download and share. Encourage your student to revisit their plans periodically to update and adjust.

WHAT IS YOUR DREAM JOB?























